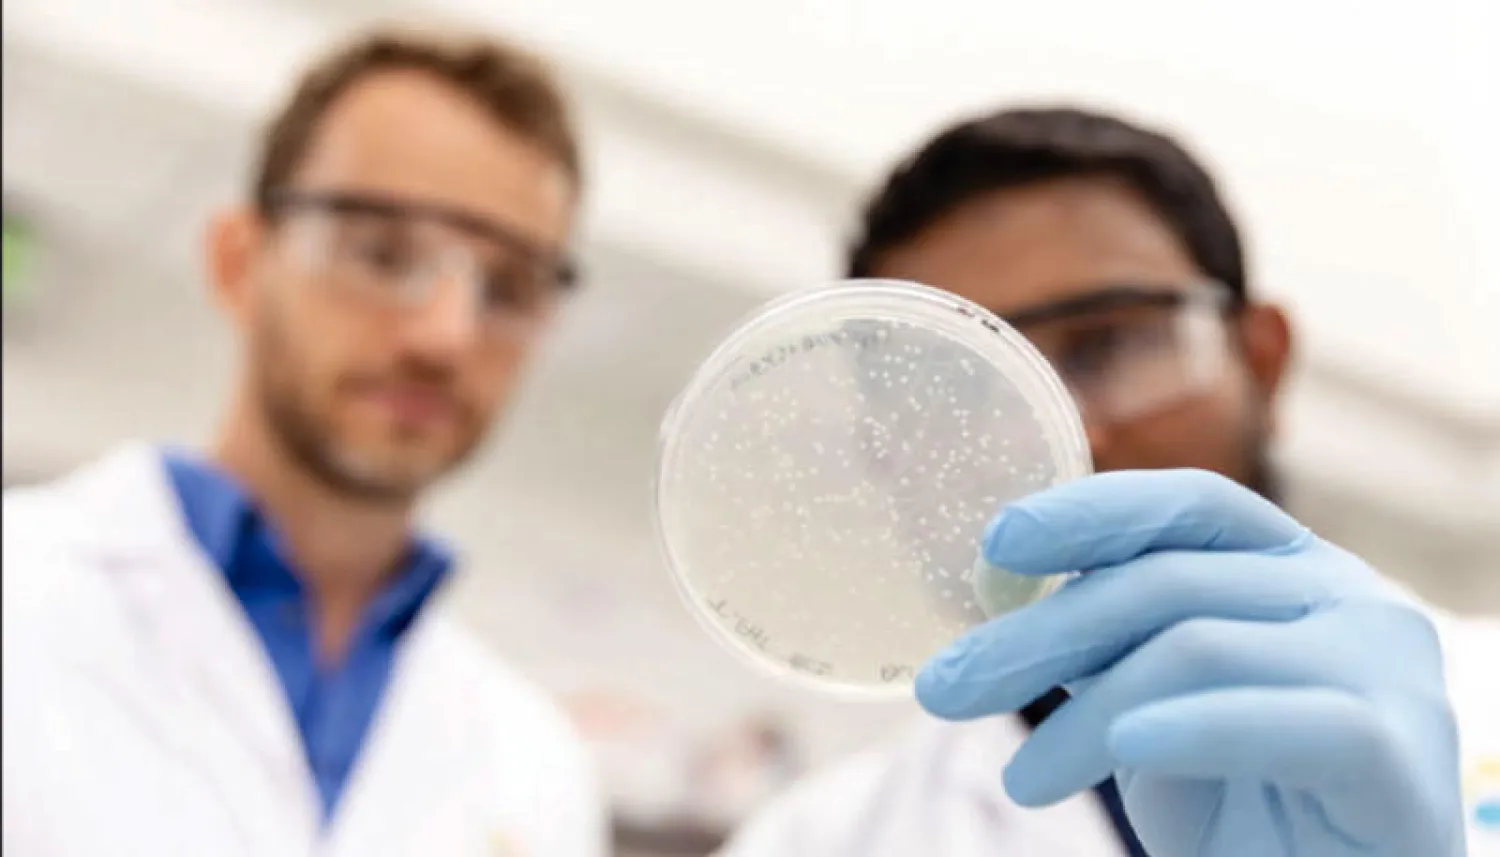
البروفيسور ستيفان أرولد (يسار) والدكتور عمر حميد يعملان  من أجل التوصل إلى فهم أفضل للكيفية  حدوث الإسهال

عند الشعور بالدفء داخل الأمعاء البشرية، وقت التمثيل الغذائي، تدب الحياة في بعض أنواع البكتيريا المُسببة للأمراض، فتُطلق السموم ومركبات أخرى ضارة للجسم. وفقاً لما جاء في دراسة مشتركة بقيادة جامعة الملك عبد الله للعلوم والتقنية (كاوست)، بشأن الطرق التي يستشعر بها بروتين مهم التغير في درجة الحرارة، ومن ثم يُفرز السموم المُسببة للإسهال.
يقول الدكتور عمر حميد، الباحث ضمن مجموعة البروفسور ستيفان أرولد في «كاوست»: «بعد تحديد كيفية استشعار البكتيريا وجودها داخل الجسم البشري، يمكننا حينئذ أن نحاول التفكير في كيفية إحداث خلل في هذه الآلية عن طريق جزيئات صغيرة، تمنع البكتيريا من التكيف مع بيئتها، وهو ما قد يُضعفها ويُسهل القضاء عليها».
وتستخدم جميع أنواع البكتيريا المتوطنة في الأمعاء، والتي تسبب الأمراض المنقولة عن طريق الغذاء، بما في ذلك «السلمونيلا» والسلالات المسببة للأمراض من بكتيريا «الإشريكية القولونية» (إي كولاي) وبكتيريا «ضمة الكوليرا» المسببة للكوليرا، بروتيناً يسمى اختصاراً H - NS، تستخدمه البكتيريا من أجل تكثيف الحمض النووي الخاص بها وتقييد التعبير الجيني إلى حد كبير، إذ يُشكل هذا البروتين مُركبات متعددة الوحدات تساعد الميكروبات علي البقاء في حالة من السُبات النسبي عندما تكون حرة طليقة في البيئة. ولكن، كما يوضح البروفسور ستيفان أرولد، أستاذ العلوم البيولوجية بكاوست وقائد المجموعة البحثية، لا بد أن تتكسر هذه المُركبات لكي يُرخي البروتين قبضته، ويسمح للبكتيريا بالنمو والازدهار داخل مُضيف من ذوي الدم الحار.
ودرس أرولد هذا البروتين لأكثر من 15 عاماً، قبل أن يلتحق بكاوست، وكان في السابق قد حدد الشكل الثلاثي الأبعاد لجزء من البروتين. ورغم إيضاحه أن مُركبات ذلك البروتين تنهار في درجة حرارة جسم الإنسان، فلم يكن واضحاً كيف يحدث ذلك.
والآن، من خلال العمل المختبري بالجامعة، نجح أرولد وحميد، بالتعاون مع الدكتور ماريوس جاريمكو، أستاذ العلوم البيولوجية المساعد بكاوست في الجمع بين التجارب المختلفة. ما مكنهم من التحديد الدقيق للجزء الخاص من البروتين، والذي يُغير تكوينه كرد فعل على أي ارتفاع في درجة الحرارة، مما يدفع مُركبات البروتين إلى التفكك والانهيار.
ساعدت عمليات المحاكاة الحاسوبية، التي أُجريت بالتعاون مع الدكتور شين جاو، أستاذ علوم الحاسب الآلي المشارك بكاوست، والدكتورة جيانينج لي، الباحثة بجامعة فيرمونت في الولايات المتحدة، الفريق البحثي على التوسع في تلك الأفكار. وفي نهاية المطاف، أثبت أعضاء الفريق أن التفكك الجزئي لمُركبات البروتين H - NS يدفعه إلى تبني شكل من أشكال التثبيط الذاتي؛ يحول بدوره دون قدرة البروتين علي الاتحاد بالحمض النووي والتعرف عليه.
ويأمل البروفسور أرولد وفريقه في أن يستطيعوا تطوير أدوية يمكنها تثبيت الارتباط بين البروتينات في درجة حرارة الجسم، ومن ثم منع مُركبات البروتين H - NS من التفكك. يقول أرولد: «إذا استطعنا العثور على مُركبات تعزز بنية البروتين وتمنعه من التفكك حال ارتفاع درجة الحرارة، فستفقد البكتيريا عندها، القدرة على إفراز السموم، حيث ستبقى ضعيفة بشكل عام داخل الجسم». ويقتل الإسهال نحو 525 ألف طفل دون سن الخامسة سنويا.
بروتين يفرز السموم المسببة للإسهال
https://aawsat.com/home/article/2439186/%D8%A8%D8%B1%D9%88%D8%AA%D9%8A%D9%86-%D9%8A%D9%81%D8%B1%D8%B2-%D8%A7%D9%84%D8%B3%D9%85%D9%88%D9%85-%D8%A7%D9%84%D9%85%D8%B3%D8%A8%D8%A8%D8%A9-%D9%84%D9%84%D8%A5%D8%B3%D9%87%D8%A7%D9%84



بروتين يفرز السموم المسببة للإسهال
دراسة ترصد نشاطه داخل بكتيريا الأمعاء لدى تعرضها للحرارة

البروفيسور ستيفان أرولد (يسار) والدكتور عمر حميد يعملان من أجل التوصل إلى فهم أفضل للكيفية حدوث الإسهال

بروتين يفرز السموم المسببة للإسهال
البروفيسور ستيفان أرولد (يسار) والدكتور عمر حميد يعملان من أجل التوصل إلى فهم أفضل للكيفية حدوث الإسهال
لم تشترك بعد
انشئ حساباً خاصاً بك لتحصل على أخبار مخصصة لك ولتتمتع بخاصية حفظ المقالات وتتلقى نشراتنا البريدية المتنوعة








